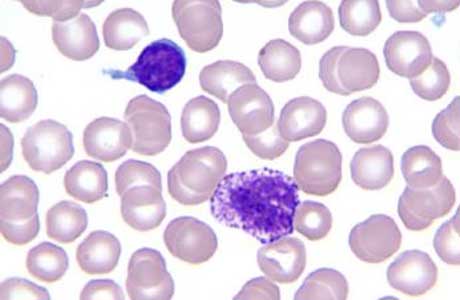

Підвищені базофіли у дорослого: про що це говорить?
Базофіли (базофільні гранулоцити) – різновид білих кров’яних клітин, які беруть участь у розвитку алергічних реакцій. Значне підвищення рівня базофілів у крові називається базофилией і може спостерігатися при деяких аутоімунних і алергічних захворюваннях.
Функції
Базофіли здатні виробляти активні речовини, які впливають на процеси запалення, кровообігу і тромбоутворення, що сприяє виконання наступних функцій:
- фагоцитоз – захоплення і знищення патогенних мікроорганізмів;
- виділення гістаміну, для поліпшення проникності судин та міграції інших видів лейкоцитів з крові в тканину при виявленні патогенних мікроорганізмів і антитіл;
- виділення гепарину для підтримки нормального кровообігу в осередках алергічного запалення;
- поліпшення трофіки тканин і утворення нових капілярів;
- участь у противопаразитарном імунітеті;
- посилення запальних процесів в епітелії кишечника і внутрішніх органів при наявності гельмінтів, а також місцевого запалення при присутності кліщів;
- синтезування біологічно активних речовин, необхідних для формування алергічних реакцій і зміни складу крові при запаленні;
- очищення організму від наслідків запалення.
Норма базофілів у крові (таблиця)
У дорослої людини рівень базофілів у крові може відрізнятися в залежності від фізіологічних особливостей організму і наявності хронічних запальних захворювань.
| Вік, років | Абсолютний показник, x10⁹/літр | Відносний показник, % |
|---|---|---|
| До 10 | 0,6 | 0-0,2 |
| 10-21 | 0,5 | 0-0,2 |
| Після 21 | 0,5 | 0-0,2 |
Причини підвищених базофілів у дорослих

Підвищення рівня базофілів може бути як реакцією організму на фізіологічні процеси, так і одним із симптомів розвитку низки системних патологій і захворювань внутрішніх органів.
Природні причини, у результаті яких відбувається збільшення кількості базофілів у периферичній крові, наступні:
- менструальний цикл у жінок;
- використання засобів контрацепції з великою кількістю естрогену в складі;
- невеликі дози радіоактивного опромінення (часті процедури рентгена);
- період відновлення після інфекцій;
- вагітність.
Патологічні причини підвищення базофілів у крові можна класифікувати наступним чином:
- алергія;
- хвороби крові;
- патологія щитовидної залози.
Алергічні реакції
Після потрапляння в організм алергену базофіли формують реакцію гіперчутливості, яка відрізняється за типом:
- анафілактичний – загальні або місцеві реакції організму на алерген, що супроводжуються вивільненням гістаміну з базофілів.
- цитотоксичний — поява антитіл до алергену викликає аутоімунний відповідь на внутрішньоклітинному рівні і гемолітичні патології.
- імунокомплексний — утворення імунних комплексів у тканинах, що викликають пошкодження кровоносних судин, суглобів, нирок і т. д.
- гіперчутливість уповільненого типу – повільний розвиток алергії на молекулярні сполуки, що утворилися в результаті тривалого впливу внутрішніх і зовнішніх алергенів (наприклад, вживання медикаментозних засобів або контакт шкіри з хромом).
Захворювання, які супроводжуються алергічними реакціями та підвищенням вмістом базофілів:
- Алергія на шерсть, метал, їжу, пилок і цвітіння рослин і т. д.
- Синдром Гудпасчера – аутоімунне захворювання з дифузним альвеолярним кровотечею і гломерулонефритом, викликаними скупченням специфічних антитіл до базальних мембранах ниркових і легеневих капілярів.
- Сироваткова хвороба – алергічна реакція, що виникає після введення ін’єкцій, розчинів і інших лікарських засобів. Імунна відповідь на чужорідні антитіла і підвищений рівень базофілів у крові може спостерігатися при використанні протидифтерійної, протівоботулініческой, протиправцевої та інших сироваток.
- Екзогенний алергічний альвеоліт – запальний процес в альвеолах і бронхіолах легенів, спричинені зовнішніми факторами впливу, такими як спори грибів, рослинна і домашній пил, бактеріальні спори, деякі медикаментозні засоби.
- Ревматоїдний артрит – системне порушення генетичного або набутого характеру і супроводжується розвитком хронічного запалення сполучної тканини дрібних суглобів.
- Системний червоний вовчак – аутоімунна патологія з запальними реакціями сполучної тканини в судинах внутрішніх органів, шкіри і т. д.
- Гломерулонефрит – запалення нирок, що виникає внаслідок низки системних хвороб (системний червоний вовчак, системний ендокардит). Гломерулонефрит викликає, поява набряків, гіпертензія, затримку сечі.
- Васкуліт – аутоімунне запалення всіх типів судин, яке призводить до порушення будови і функцій всіх внутрішніх органів.
- Контактний дерматит – подразнення шкіри у результаті негативного впливу зовнішнього середовища. При контактному дерматиті базофіли скупчуються в уражених тканинах і викликають набряки, поява бульбашок, ерозії, лущення.
- Бронхіальна астма – алергічна хвороба дихальних шляхів, яка зумовлена функціональними змінами роботи імунних клітин. Астма супроводжується виділенням слизу, кашлем, утрудненим диханням, задухою.
- Цукровий діабет першого типу – захворювання ендокринної системи з ураженням клітин підшлункової залози і недостатнім виділенням інсуліну. До основних симптомів цукрового діабету 1 типу відносять гіпоглікемію, зниження засвоюваності їжі, посилену спрагу.
Захворювання крові
Захворювання крові (мієлопроліферативні) – це порушення в роботі кісткового мозку, в результаті яких відбувається підвищення вироблення стовбурових клітин, а також неправильні процеси дозрівання зернистих лейкоцитів. При міелопроліферативних патологіях базофіли та інші форми лейкоцитів значно підвищуються, а також змінюється число еритроцитів і тромбоцитів:
- Хронічний мієлолейкоз — патологічне розростання тканин, що утворюють всі види зернистих лейкоцитів. В результаті розвитку мієлолейкозу в плазмі підвищується рівень моноцитів, базофілів, еозинофілів. На запущеній стадії хвороба проявляється дистрофічними змінами серця, нирок, печінки, селезінки, а також інтоксикацією, частими кровотечами, гнійно-запальними процесами.
- Еритремія (поліцитемія) – хронічне порушення гемопоезу з патологічним збільшенням кількості еритроцитів і деяких форм лейкоцитів, гіпертрофією кров’яного русла і зниженням функціональності внутрішніх органів. Еритремія проявляється, переважно, у дорослих людей у віці від 40 до 60 років.
- Мієлофіброз – порушення процесів кровотворення в результаті заміщення кісткового мозку сполучною тканиною. При миелофиброзе в плазмі спостерігається велика кількість незрілих форм базофілів, моноцитів, лімфоцитів, еозинофілів і еритроцитів, а також діагностується анемія, збої в роботі селезінки, печінки і т. д.
- Лімфогранулематоз (рак Ходжкіна) – поява злоякісних пухлин в лімфатичних вузлах. В деяких формах лимфогрануматулеза проявляється значне збільшення всіх форм лейкоцитів.
Гіпотиреоз
При гіпотиреозі в організмі розвивається дефіцит тиреоїдних гормонів (Т3 і Т4). В результаті гормонального дисбалансу порушуються процеси кровотворення, що відбуваються в кістковому мозку. У деяких випадках патологія супроводжується наявністю підвищених базофілів, нейтрофілів та еозинофілів.